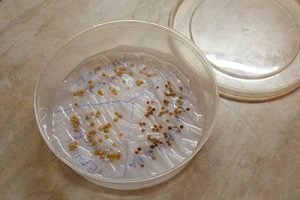
Ріпа: посадка і догляд у відритому грунті

Ріпа, турнепс та різні варіанти редьки — це продукти, які широко застосовується в приготуванні страв. Їх можна зустріти в різних супах, салатах і в чому іншому.
Але мало хто замислюється, що для того щоб виростити цей продукт в середній смузі, часто доводиться докласти не мало зусиль, і багаж знань при цьому повинен бути досить великим.
Тільки ріпа, зросла з дотриманням всіх норм і при правильному догляді, може похвалитися своїм особливим і точним смаком.
Багато хто вважає, що ріпка, здатна замінити картоплю в деяких стравах. Вирощувати її в Сибіру і на Уралі, особливо складно, а, наприклад, в Підмосков’ї, де переважають рівнинні місцевості, набагато простіше.
Зміст:
- Як вибрати розташування і підібрати грунт
- Добриво
- Як відібрати та підготувати насіння
- Розсадний метод
- Безрассадный спосіб
- Як грамотно доглядати
- Важливість деревної золи
- Як зберігати після збору
Як вибрати розташування і підібрати грунт

Перед тим як займатися посівом, треба вибрати сорт і місце в якому буде проводитися посадка на вашій дачі.
Відмінно може підійти дачну ділянку з виділеною територією (залежно від розміру) під вирощування.
Садівники радять: краще всього підібрати таке місце, де грунт найбільш плодюча, це дозволить мінімізувати кількість насіння, що не зійдуть.
Не рекомендується ховати рослина в тінь, так як воно потребує в постійному доступі прямих або розсіяних сонячних променів. Чим більше світла воно отримує, тим швидше дозріє. В разі чого, можна зробити вапнування грунту.
Добриво

Удобрювати доведеться лише навесні. Робити це необхідно в тому випадку, якщо поживні речовини в грунті закінчилися і вона зневоднена. Такий бідний склад без праці усувається перегноєм.
Рекомендація садівника: зола — відмінне недороге добриво. Вона є цінним джерелом таких мінеральних речовин, як калій, магній, натрій, необхідних для повноцінного розвитку і росту рослин.
Приблизно половину відра золи необхідно помістити на квадратний метр. Не варто економити, так як краще переборщити з її кількістю. Не рекомендується удобрювати гноєм, так як при цьому форма плоду може змінитися, і він втратить свій смак.
Рекомендується робити посадки на тому місці, де якийсь час до цього були вирощені помідори, огірки або інша зелень. Не варто садити після таких попередників як редис і капуста. Не рекомендується це тому що всі ці рослини мають одній, властивої кожному з них, хворобою. При повторному вирощуванні схожого продукту, ймовірність його зараження дуже велика.
Як відібрати та підготувати насіння
Ймовірність сходження насіння ріпи «Гейша», досить велика.
Під час покупки варто стежити за тим щоб семеня були:
- свіжими;
- добре упакованими;
- не видавали неприємного запаху.
Рада садівника: якщо ви хочете досягти максимального коефіцієнта схожості, то потрібно провести спеціальну процедуру замочування насіння в шматку тканини.
Сама тканина змочується в двох рідинах:
- воді, при температурі 40 градусів;
- розчині марганцівки.
Після того як насіння полежать в просоченої тканини протягом 5 хвилин, їх потрібно витягнути і ретельно просушити до того стану, при якому вони стануть сипучими. Насіння відрізняються своїм невеликим розміром, тому сходи не можуть бути надто густим. Вирішення цієї проблеми є, для цього потрібно змішати чайну ложку насіння зі склянкою піску. Вони поширяться в достатній кількості і прямо в цьому виді їх можна сіяти.
Розсадний метод

В інтернеті можна знайти масу відео і фото з детальним розглядом цього способу. Для того щоб отримати урожай в найкоротші терміни, можна використовувати розсадний метод. Насіння в ємності потрібно садити в лютому. Варто подбати про те, щоб земля була насиченою, але при цьому легкою.
Для досягнення цього результату змішують кілька інгредієнтів:
- торф;
- пісок;
- родючу землю.
Сіяти насіння потрібно по 3 штуки на відстані 10 сантиметрів один від одного. Не потрібно закопувати їх занадто глибоко, достатньо буде 1 сантиметра. Така невелика глибина необхідна тому, що пагони будуть не такими сильними при відсутності світла.
Садівники пропонують: після того як насіння посаджені, в очікуванні перших паростків потрібно прикрити контейнер спеціальним прозорим склом, через яке можна спостерігати за швидкістю і якістю паростків.
В процесі поливання потрібно бути особливо обережним і уникати утворення особливої кірки. Місце для зберігання потрібно виключно сонячне, це дозволить листю бути більш твердими і швидше пробиратися через грунт.
Після того, як утворилося 2 листка, паростки проріджують. Робиться це для того, щоб позбутися від найслабкіших і залишити тільки сильні пагони.
У середині квітня рекомендується почати переміщення паростків з розсади в грунт. У квітні грунт достатньо прогріта і, завдяки цьому, рослини не ушкодяться під впливом палючого сонця або навпаки не замерзнуть в холодному, відкритому грунті.
Безрассадный спосіб

При безрозсадному методі рекомендується використовувати різні варіанти агротехніки, і робити це краще при зростаючому місяці.
Для того, щоб отримати максимально багато врожаю, садити можна два рази за рік.
Якщо ви хочете зібрати річний урожай, то посадку потрібно проводити на початку травня, бажано в першу тиждень.
При зимовому зборі, садити потрібно на початку липня.
Сам процес посадки можна розділити на кілька етапів, серед яких:
Як грамотно доглядати
 Для того, щоб домогтися великої кількості зійшли рослин, потрібно застосовувати ряд порад, які допоможуть домогтися якісного врожаю.
Для того, щоб домогтися великої кількості зійшли рослин, потрібно застосовувати ряд порад, які допоможуть домогтися якісного врожаю.
При відсутності достатньої кількості вологи, ріпа «Петровська» може втрачати свій первинний смак, і відповідно її якість буде знижуватися. Вона може грубіти або зовсім бути сухою. Щоб уникнути цього, потрібно регулярно проводити полив, у кількості одного або двох разів на тиждень.
Ріпа потребує великої кількості води, тому рекомендується використовувати 10 літрів на квадратний метр.
Для того, щоб листя піднімалися рівне, потрібно видаляти всі бур’яни, які можуть зашкодити їм. У тому разі, якщо зростання листя йде дуже повільно, для стимуляції можна використовувати стимулюючі препарати, наприклад «Епін».
Другим рішенням цієї проблеми може бути створення добрива. Зробити це досить легко, потрібно розбавити «Магбор» в пропорції: одна столова ложка на одне відро. Ріпа має бути насичена бором, потрібно це для того, щоб усередині не утворювалися порожнечі, які знизять її вага при великому розмірі.
Важливість деревної золи

Перед кожним розпушуванням, найкраще обробити грунт деревною золою. При великій кількості часу і бажання робити це можна кожен день. Цей спосіб обробки захистить від бліх. Вони дуже небезпечні для врожаю, особливо в тому випадку, якщо ріпа була пізно посаджена.
Не варто боятися шкоди цих комах в нічний час, так як вони сплять вдень. А ось для того, щоб захистити рослину в денний час, потрібно створити «нічний укриття». Їм і служить покрита попелом поверхню.
Як зберігати після збору

Після того як продукт підійшов до дозрівання, потрібно виконати його правильний збір, не пошкодивши тонку систему рослин. У тому випадку, якщо діаметр плодів більше 10 сантиметрів, його не рекомендується вживати в їжу, так як він вважається переростком. Еслі ріпа була пізно посаджена, потрібно ретельно поливати, і організувати збір до настання температури нижче 0?С.
Отримувати ріпу з землі дуже легко, і робити це потрібно одним різким рухом. Після цього потрібно відрізати всю бадилля, але уважно стежити за станом самого коренеплоду, його потрібно не пошкодити. Зберігати всю продукцію потрібно при температурі 2-3 градуси.
Не рекомендується тримати на зберіганні більше половини року, за цей час її необхідно реалізувати або вжити в їжу. Місце повинно бути сухим, інакше вся продукція зіпсується за досить короткий проміжок часу.
Дивіться відео, в якому досвідчений садівник розповідає як виростити споконвічно російська овоч — ріпу:
